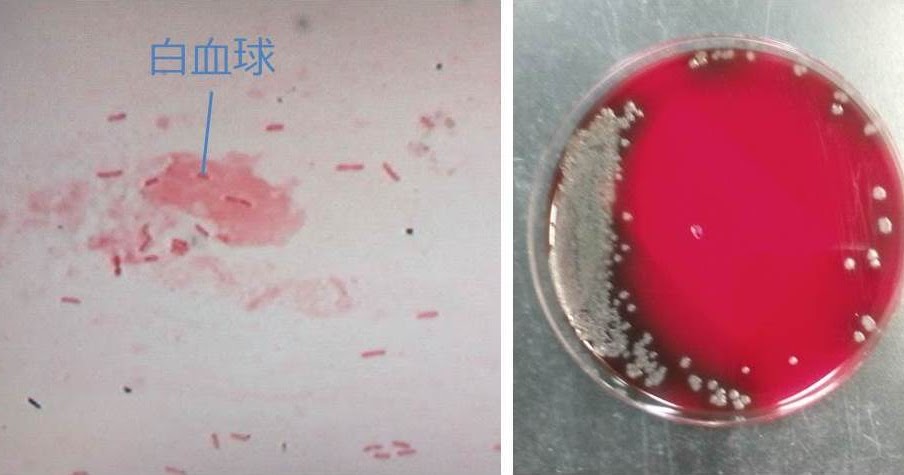
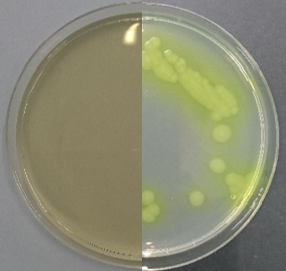
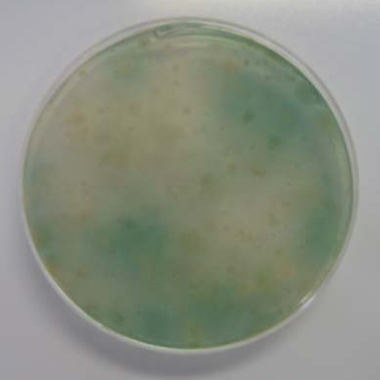

緑膿菌 写真 (272 無料画像)
高齢者が気をつけたい緑膿菌感染症 症状と予防策を専門家が解説介護の教科書みんなの介護。
P.aeruginosa with mucoid緑膿菌:ムコイド産生型グラム染色: Gram Stain。
細菌の鑑別 緑膿菌 写真素材5367677- フォトライブラリ。
受注生産品 緑膿菌分離培養用 NAC寒天培地株式会社アテクト。
緑膿菌による角膜感染症の原因や症状は?角膜 黒目 の傷から感染するとどうなる?アキュビュー®公式。
細菌の鑑別 緑膿菌 写真素材5367661- フォトライブラリ。
看護教育のための情報サイト「NurSHARE」 記事・コラム企画。
緑膿菌をだまし討ち! 鉄分の供給遮断による新規緑膿菌増殖阻害法の開発に成功ハイライト論文名古屋大学 学術研究・産学官連携推進本部。
東京大学大学院医学系研究科 健康科学・看護学専攻 老年看護学 創傷看護学分野。
microbiology round - 亀田総合病院 感染症内科。
東京大学大学院医学系研究科 健康科学・看護学専攻 老年看護学 創傷看護学分野。
シュードモナス エルギノーザ菌の図鑑ヤクルト中央研究所。
緑膿菌 Pseudomonas aeruginosa。
ドリルのパワー! パート2 - はっとり皮膚科医院。
緑膿菌による角膜感染症の原因や症状は?角膜 黒目 の傷から感染するとどうなる?アキュビュー®公式。
緑膿菌」の写真素材12,552件の無料イラスト画像Adobe Stock。
緑膿菌 細菌105198919 の写真素材 - アフロ。
緑膿菌感染症 Pseudomonas aeruginosa infection– 感染症 - 神戸きしだクリニック 神戸市中央区。
こんな症例が治ります シリーズ 134犬の緑膿菌性中耳炎も 的確な治療で治します。大和市のCT完備の動物病院湘北どうぶつ次世代医療センター・CTセンタ。
緑膿菌をだまし討ち! 鉄分の供給遮断による新規緑膿菌増殖阻害法の開発に成功ハイライト論文名古屋大学 学術研究・産学官連携推進本部。
これが緑膿菌。GNRのsmallです。 患者は急性前立腺炎で、これは尿検体です。 普段はなかなか緑膿菌はお目にかからない気がしますが、細菌検査室から報告があってから「まだあのスライドガラス残ってますか?」と技師さんに聞いてみると良いです。どれがGNR middleでどれ。
緑膿菌が抗菌剤を菌体外に排出し、多剤耐性化する仕組みを解明-阪大 - QLifePro 医療ニュース。
染方史郎の3分細菌楽#005モンスター系の細菌たち~緑膿菌とその仲間金子幸弘染方史郎の3分細菌楽メディカLIBRARY。

Pseudomonas< span>属_微生物検査検査・診断Matrix" loading="lazy" >
ダウンロード
菌種別 Pseudomonas< span>属_微生物検査検査・診断Matrix。
40点を超える緑膿菌 イラストのストックフォト、写真、そしてロイヤリティフリーの画像 - iStock。
緑膿菌の代謝産物をヒトの薬剤にChem-Stationケムステ。
138 緑膿菌 Stock Photos, High-Res Pictures, and Images - Getty ImagesPseudomonas, バイオフィルム, 黄色ブドウ球菌。
研究イメージ 緑膿菌の写真素材57586648- PIXTA。
CHARACTER - TVアニメ『はたらく細胞』公式サイト第2期制作決定。
 Pseudomonas< span>属_微生物検査検査・診断Matrix" loading="lazy" >
ダウンロード
Pseudomonas< span>属_微生物検査検査・診断Matrix" loading="lazy" >
ダウンロード